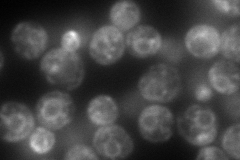
YPR113W
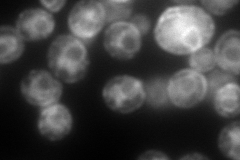
YPR113W
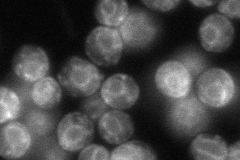
YPR113W
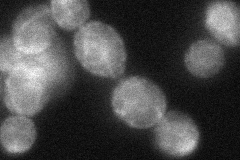
YPR113W
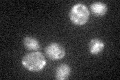
YPR113W

View description
Phosphatidylinositol synthase, required for biosynthesis of phosphatidylinositol, which is a precursor for polyphosphoinositides, sphingolipids, and glycolipid anchors for some of the plasma membrane proteins
Localization:
Intensity:
Fold change:
Significance:
-
C’ GFP library in SD

punctate,ER52.52 -
N' NOP1pr-GFP in SD
ER,punctate174.565 -
N' TEF2pr-mCherry in SD
ER,vacuole278.568 -
N' NATIVEpr-GFP in SD
ER83.2779 -
N' TEF2pr-VC and Cyto-VN in SD
ER,punctate54.262 -
C’ GFP library in SD+DTT

punctate,ER58.321.11No -
C’ GFP library in SD+H2O2

punctate,ER48.710.92No -
C’ GFP library in Starvation Media
punctate,ER37.50.71No -
C’ GFP library on the background of Pup2-DaMP

N/A -
C’ GFP library on the background of CCT mutant

N/A0N/AYes
